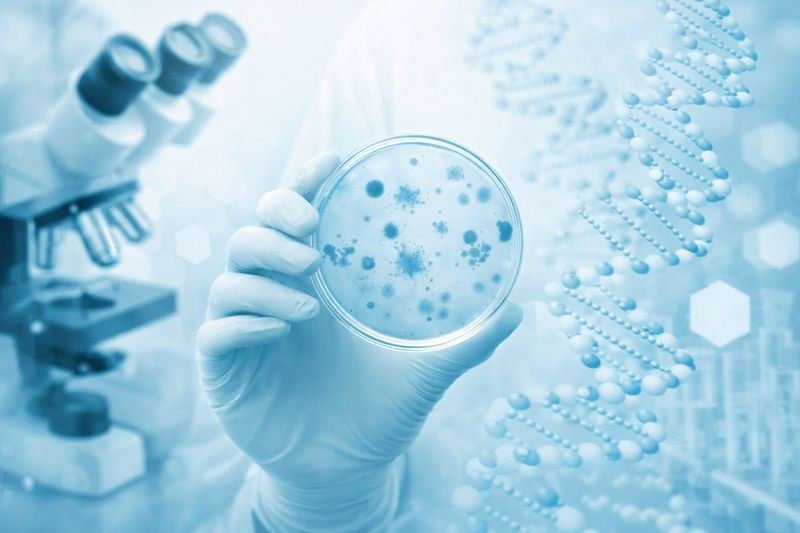

Как подготовиться к тесту ДНК
У генетического исследование, как и у любого анализа есть свои правила. Их нужно соблюдать перед сдачей образцов, чтобы анализ получился точным. Существуют общие требования и частные случаи для определённого вида теста ДНК. Рассмотрим их в данной статье.
Общие требования для подготовки к ДНК-тесту
Эти требования относятся именно к подготовке исследуемого лица к сдаче биологического материала.
- Ротовой мазок. Рекомендации для взрослого человека и ребенка, который уже не на грудном вскармливании. Перед сдачей образца за 2 часа до приема нельзя кушать и жевать жевательную резинку, не курить и не пить алкоголь. Последние пункта, надеемся, не относится к детям.
Для грудных детей. Не кормить грудью за два часа до сдачи образцов. После кормления промыть рот теплой водой.
- Венозная кровь для неиназивных пренатальных тестов (НИПТ). В крови матери должна быть достигнута определенная концентрация ДНК ребенка. Как правило, такая концентрация достигается к 8-9 недели беременности. Раньше этого срока есть вероятность, что тест получится, но она уже не очень высокая. Других ограничений по крови нет.
Ниже рассмотрим требования к самому биологическому материалу. Какие ошибки не стоит допускать.
- Любой ДНК образец должен содержать только одну ДНК. Если образец загрязнен чужой ДНК, тест не получится.
- Хранить образцы (кроме жидкой крови и плазмы) нужно при комнатной температуре. Нельзя подвергать высоким температурам или замораживать. Обработка концентрированными химикатами также запрещена.
- Влагосодержащие образцы, например, ротовой мазок хранить в бумажной упаковке, чтобы не появилась плесень.
- Жидкую кровь и плазму лучше хранить при 5-7 градусах Цельсия. Можно в дверке холодильника, но не в морозилке!
Подготовка к тесту ДНК (не образцы)
Помимо образцов существуют и другие аспекты подготовки к генетическому исследованию:
- На любой ДНК анализ лучше записываться заранее, чтобы не ждать других пациентов и не тратить время.
- Если исследование носит юридический характер, например, ДНК тест для суда, то необходимо приготовить документы. Документы должны быть в оригиналах.
- Также на судебный тест надо явиться всем участникам анализа для идентификации, так что лучше позаботиться заранее и оповестить их.
Ну и конечно же лучше сперва получить консультацию специалистов ДНК лаборатории, чтобы обладать всей информацией и подготовиться к ДНК теста заранее и полностью.